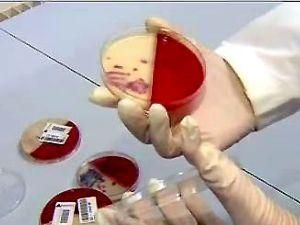
Небезпечну кишкову паличку знайшли у струмку у Франкфурті-на-Майні Небезпечну кишкову паличку знайшли у струмку у Франкфурті-на-Майні

Струмок протікає в безпосередній близькості від однієї з ферм, де вирощувався салат, на листі якого раніше були виявлені небезпечні бактерії.
За словами представника міністерства соціального забезпечення землі Гессен, вода струмка Ерленбах не потрапляє у водопровідну мережу.
"Тому небезпека зараження питної води відсутня", — запевнила представник міністерства соціального забезпечення та навколишнього середовища федеральної землі Гессен.